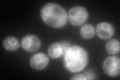
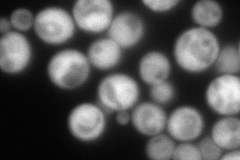
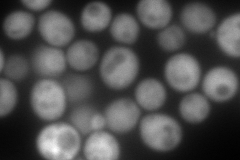
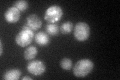

View description
Guanine nucleotide exchange factor for Gpa1p; amplifies G protein signaling; subunit of the GET complex, which is involved in Golgi to ER trafficking and insertion of proteins into the ER membrane; has low-level ATPase activity
Localization:
Intensity:
Fold change:
Significance:
-
C’ GFP library in SD
ER88.94 -
N' NOP1pr-GFP in SD
cytosol271.431 -
N' TEF2pr-mCherry in SD
cytosol414.366 -
N' NATIVEpr-GFP in SD

cytosol128.538 -
N' TEF2pr-VC and Cyto-VN in SD

cytosol68.9837 -
C’ GFP library in SD+DTT

ER89.551No -
C’ GFP library in SD+H2O2

ER107.61.2No -
C’ GFP library in Starvation Media
ER101.111.13No -
C’ GFP library on the background of Pup2-DaMP

ER -
C’ GFP library on the background of CCT mutant

ER89.63211.00774No
